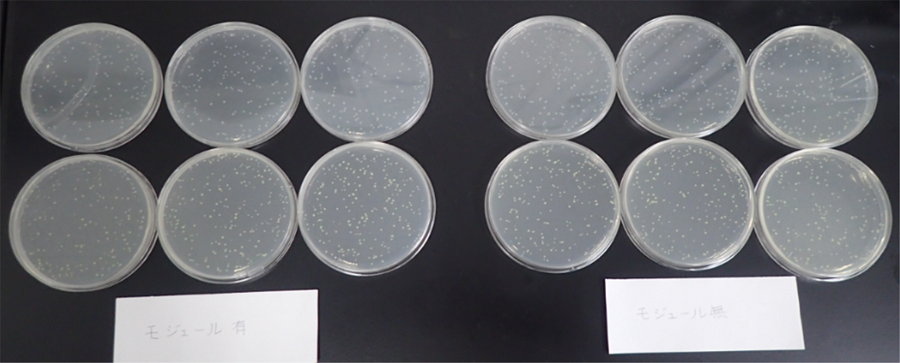

第35回においかおり環境学会
(2023.08)
微生物培養時の臭気に対する真空紫外線の脱臭効果
内藤 敬祐1 寺田 庄一1 鈴木 貴之1 西尾 謙吾1
1ウシオ電機株式会社
1.はじめに
微生物は食品や廃水処理、衛生対策機器の評価など様々な産業で活用されている。微生物を扱う際には培地を用いて増殖させる培養工程が必須であり、その際に臭気が発生する。特にインキュベータは密閉構造のため臭気がこもり、培養完了時に微生物を取り出す際、室内に臭気が拡散し、在室者に不快感を与える。微生物の培養に影響与えることなく脱臭するため、インキュベータ内に真空紫外線を用いた小型脱臭器を入れて大腸菌及び黄色ブドウ球菌を培養し、脱臭器有無による臭気の違いを分析した。ここで、真空紫外線とは、波長が200 nmより短波長の光を指す。
2.実験方法
φ90シャーレに標準寒天培地を作成し、生理食塩水で100~300 CFU/plateになるよう希釈した大腸菌(Escherichia coli, NBRC No.106373)及び黄色ブドウ球菌(Staphylococcus aureus, NBRC No.12732)を0.1 mL塗抹した試験平板を各75枚用意し、インキュベータ(EI-700B, アズワン, 135 L)に投入、37±1 ℃で24 h培養した。脱臭器はエキシマランプ(UXFL55-172UI-Z01, ウシオ電機)とオゾンを除去する触媒、臭気を取り込むためのファンを組合せた試作品(W380×D55×H90 mm、0.1 m3/min)である。オゾンは大気中の酸素の光分解により生成し、微生物の増殖に影響するため除去する必要がある。
大腸菌及び黄色ブドウ球菌の生育状況をコロニー数計測で判定した。臭気をVOC濃度計(ppbRAE-3000 10.6eV, RAE systems)でリアルタイム計測、6名(女2、男4)のパネラーによる臭気強度測定、ニオイ識別装置 (GC-FID, HERACLES Neo/M/5W, アルファモスジャパン)により計測した。
図1 実験装置図
3.結果と考察
図2に脱臭器有無による微生物生育状況を示す。脱臭器の作動による微生物の生育に影響はなかった。
脱臭処理後のVOC濃度変化を図3に、ニオイ識別装置クロマトグラムの変化を図4に示す。両者ともに脱臭器は非常に有効に働いていることを示している。官能評価結果は、脱臭器有りの臭気強度は2、脱臭器無しは4であった。この官能評価でも脱臭効果の確認ができた。
真空紫外線源として用いたエキシマランプは波長172 nmの光を放射するランプである。この波長の光は従来の水銀を用いた低圧水銀灯(オゾンランプ)よりも50倍以上酸素と水に吸収されるため、ランプ周辺にOHラジカルや酸素原子、オゾンなどの活性酸素種が高密度に生成される1), 2), 3)。そのため、脱臭器内に取り込まれた臭気は酸化分解され、最終的には二酸化炭素と水にまで分解される。脱臭原理が酸化分解反応であるため、活性炭等の吸着を利用したものと異なり破過や吸着限界は発生しないことが大きなメリットである。
今回の結果から、真空紫外線は微生物由来の臭気成分に対して強力な脱臭効果を発揮すること、適切にオゾンを脱臭器内で分解処理することで微生物生育に影響を与えないことが確認できた。
表1 シャーレ150枚のコロニー数

図2 微生物生育状況
図3 インキュベータ内のVOC濃度
図4 培養完了時のニオイ識別装置クロマトグラム
4.参考文献
1) 津野 洋:オゾンハンドブック、サンユー書房、H28年10月、P285-292
2) M.Ackerman et al:UV-solar radiation related to mesospheric processes, Mesospheric Models and Related
Experiments, pp.149-159, 1971
3) S.P. Sander et al:Chemical Kinetics and Photochemical Data for Use in Atmospheric Studies, Evaluation No. 17,
JPL Publication 10-6, 2011
4) Katsumi Umano et al:Volatile chemicals formed in the headspace of a heated D-Glucose/L-Cysteine maillard model
system, J. Agric. Food Chem. Vol.43, No.8, 1995
キーワード:エキシマランプ、脱臭、酸化分解、微生物